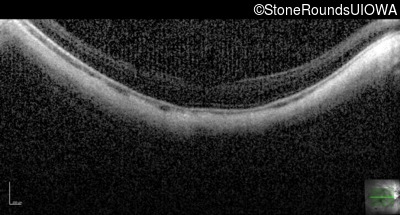
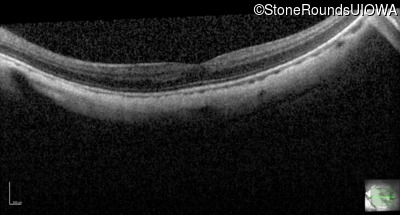

Case
SR648
Student Mode
AR CSNB, normal fundus (IA2fiii)
Male
Male
Hidden
SR648
Student Mode
AR CSNB, normal fundus (IA2fiii)
Male
Male
History
This 16 year old male has had poorer vision in dim light than his siblings since childhood. He has also been very myopic since childhood and is currently wearing -14.00 diopter spectacles. The maximum combined response of the electroretinogram reveals a selective loss of the b-wave.
| Age at visit: 18 years |
Diagnosis & molecular findings
| Disease | Gene | Allele 1 variant(s) | Allele 2 variant(s) | Inheritance mode |
|---|---|---|---|---|
| AR CSNB, normal fundus | TRPM1 | Lys18 del18aAGGTGAGTGAGCTTTGCC | Tyr72Cys TAT>TGT | AR |
Disease:
Gene:
Allele 1:
Lys18 del18aAGGTGAGTGAGCTTTGCC
Allele 2:
Tyr72Cys TAT>TGT
Inheritance:
AR